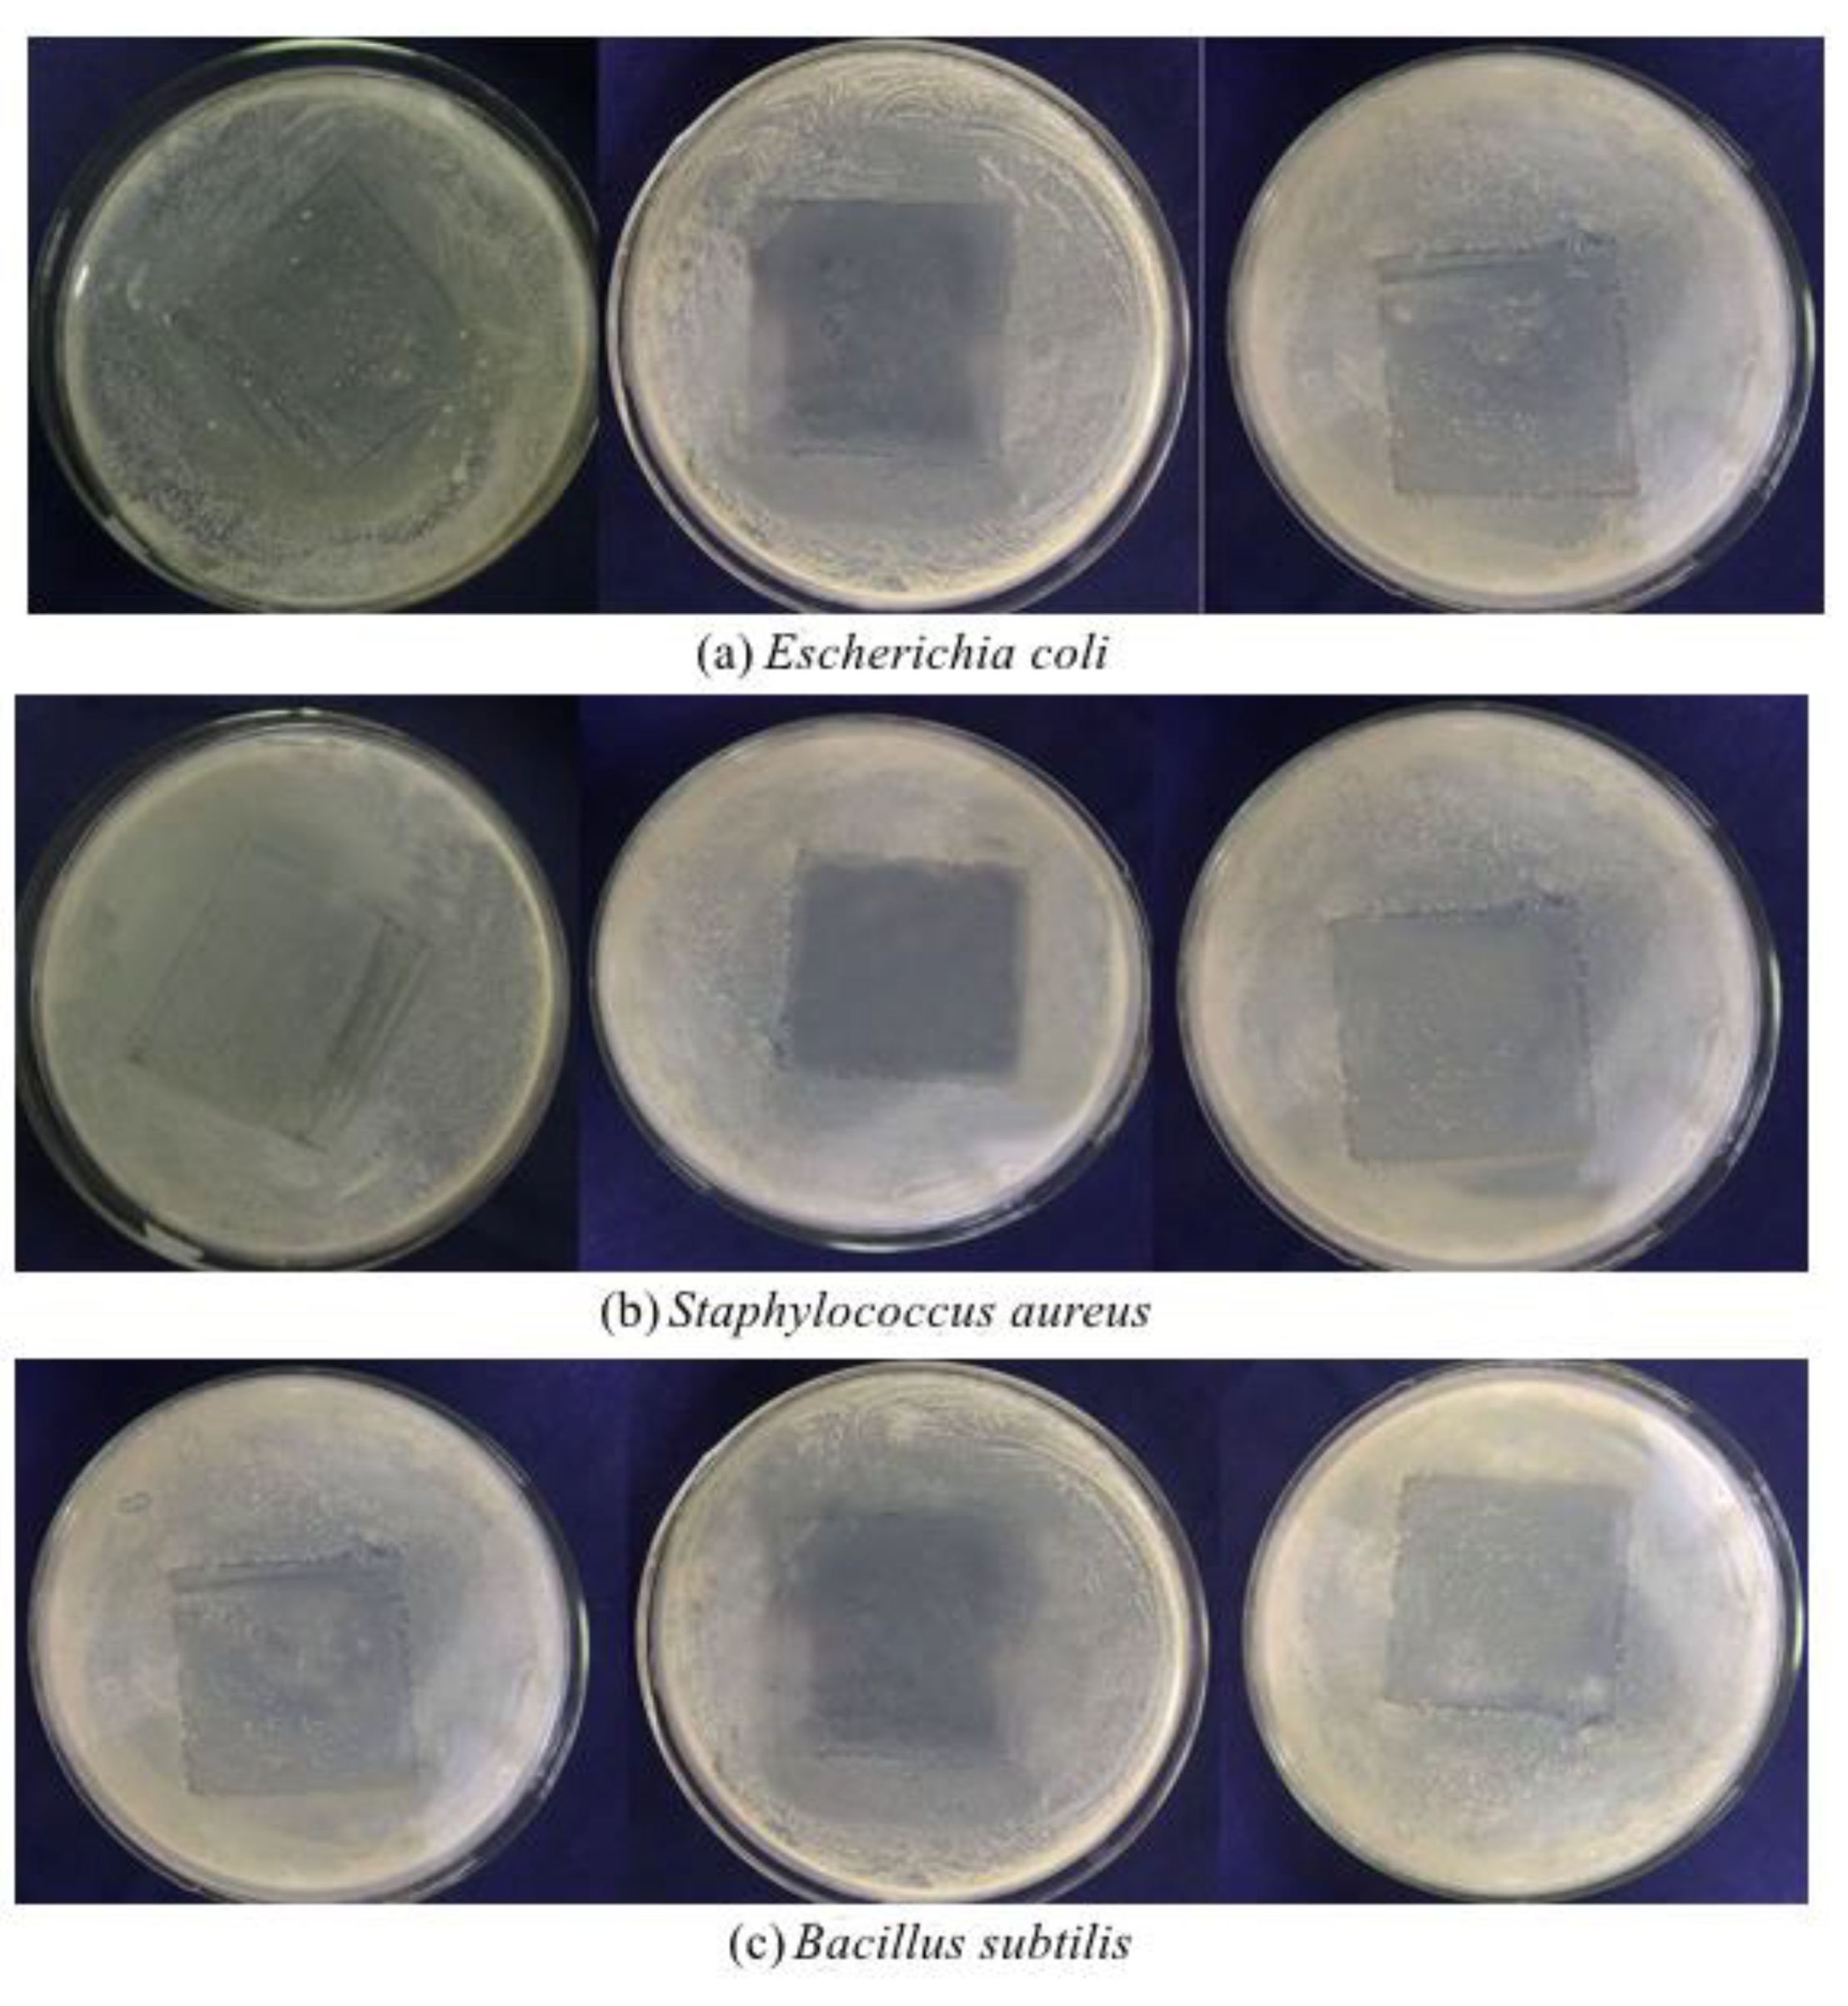
Foods 10 02268 g005 550

Preparation and Characterization of Ginger Essential Oil Microcapsule Composite Films
Abstract
:1. Introduction
2. Materials and Methods
2.1. Materials
2.2. Preparation of Ginger Essential Oil Microcapsules
2.3. Preparation of Ginger Essential Oil Microcapsule Composite Films
2.3.1. Preparation of Microcapsule Films
2.3.2. Optimization of Preparation Conditions of Ginger Essential Oil Microcapsules Films
2.4. Microcapsule Characterization
2.4.1. Fourier-Transform Infrared Spectroscopy (FTIR)
2.4.2. Differential Scanning Calorimetry (DSC)
2.5. Characterization of Composite Films of Ginger Essential Oil Microcapsules
2.5.1. Thickness Measurement
2.5.2. Determination of Mechanical Properties
2.5.3. Oxygen Permeability Test
2.6. SEM
2.7. Determination of Antioxidant Properties
- (1)
- Determination of DPPH· scavenging rate
- (2)
- Determination of ABTS+ scavenging rate
2.8. Determination of Antibacterial Activity
2.9. Statistical Analysis
3. Results and Discussion
3.1. Characterization of Microcapsules
3.1.1. FTIR
3.1.2. DSC
3.2. Optimization of Preparation Conditions of Ginger Essential Oil Microcapsules Films
- (1)
- Added amount of gelatin
- (2)
- Gelatin:glycerin ratio
- (3)
- Drying conditions
- (4)
- The dosage of microcapsules
3.3. Mechanical Properties and Oxygen Permeability of Ginger Essential Oil Microcapsule Composite Films
3.4. SEM
3.5. Analysis of Antioxidant Properties
3.6. Analysis of Antibacterial Activity
4. Conclusions
Author Contributions
Funding
Institutional Review Board Statement
Informed Consent Statement
Data Availability Statement
Acknowledgments
Conflicts of Interest
References
- Hoferl, M.; Stoilova, I.; Wanner, J.; Schmidt, E.; Jirovetz, L.; Trifonova, D.; Stanchev, V.; Krastanov, A. Composition and comprehensive antioxidant activity of ginger (Zingiber officinale) essential oil from Ecuador. Nat. Prod. Commun. 2015, 10, 1085–1090. [Google Scholar] [CrossRef] [PubMed] [Green Version]
- Sharma, P.K.; Singh, V.; Ali, M. Chemical composition and antimicrobial activity of fresh rhizome essential oil of Zingiber officinale roscoe. Pharmacogn. J. 2016, 8, 185–190. [Google Scholar] [CrossRef] [Green Version]
- Babasheikhali, S.R.; Rahgozar, S.; Mohammadi, M. Ginger extract has anti-leukemia and anti-drug resistant effects on malignant cells. J. Cancer Res. Clin. Oncol. 2019, 145, 1987–1998. [Google Scholar] [CrossRef] [PubMed]
- Avanco, G.B.; Ferreira, F.D.; Bonfim, N.S.; dos Santos, P.A.D.R.; Peralta, R.M.; Brugnari, T.; Mallmann, C.A.; de Abreu, B.A.; Mikcha, J.M.G.; Machinski, M. Curcuma longa L. essential oil composition, antioxidant effect, and effect on Fusarium verticillioides and fumonisin production. Food Control 2016, 73, 806–813. [Google Scholar] [CrossRef]
- Intorasoot, A.; Chornchoem, P.; Sookkhee, S.; Intorasoot, S. Bactericidal activity of herbal volatile oil extracts against multidrug-resistant Acinetobacter baumannii. J. Intercult. Ethnopharmacol. 2017, 6, 218–222. [Google Scholar]
- da Silva, I.M.; Zanuncio, J.C.; Brugger, B.P.; Soares, M.A.; Zanuncio, A.J.V.; Wilcken, C.F.; Tavares, W.D.; Serrao, J.E.; Sediyama, C.S. Selectivity of the botanical compounds to the pollinators Apis mellifera and Trigona hyalinata (Hymenoptera: Apidae). Sci. Rep. 2020, 10, 4820. [Google Scholar] [CrossRef] [PubMed] [Green Version]
- Ali, A.; Hei, G.K.; Keat, Y.W. Efficacy of ginger oil and extract combined with gum arabic on anthracnose and quality of papaya fruit during cold storage. J. Food Sci. Technol. 2016, 53, 1–10. [Google Scholar] [CrossRef] [Green Version]
- Herve, T.; Raphael, K.J.; Ferdinand, N.; Laurine Vitrice, F.T.; Gaye, A.; Outman, M.M.; Willy Marvel, N.M. Growth performance, serum biochemical profile, oxidative status, and fertility traits in male Japanese quail fed on ginger (Zingiber officinale, Roscoe) essential oil. Vet. Med. Int. 2018, 2018, 7682060. [Google Scholar]
- Bakry, A.M.; Abbas, S.; Ali, B.; Majeed, H.; Abouelwafa, M.Y.; Mousa, A.; Liang, L. Microencapsulation of oils: A comprehensive review of benefits, techniques, and applications. Compr. Rev. Food Sci. Food Saf. 2016, 15, 143–182. [Google Scholar] [CrossRef]
- Fernandes, R.V.D.; Borges, S.V.; Silva, E.K.; da Silva, Y.F.; de Souza, H.B.; do Carmo, E.L.; de Oliveira, C.R.; Yoshida, M.I.; Botrel, D.A. Study of ultrasound-assisted emulsions on microencapsulation of ginger essential oil by spray drying. Ind. Crop. Prod. 2016, 94, 413–423. [Google Scholar] [CrossRef]
- Zhang, Y.; Zhang, H.; Wang, F.; Wang, L.X. Preparation and properties of ginger essential oil beta-cyclodextrin/chitosan inclusion complexes. Coatings 2018, 8, 305. [Google Scholar] [CrossRef] [Green Version]
- Racoti, A.; Rusen, E.; Diacon, A.; Dinescu, A.; Buleandra, M.; Calinescu, I. Ginger essential oil encapsulation in PMMA microcapsules. I. Mater. Plast. 2016, 53, 357–360. [Google Scholar]
- Simon-Brown, K.; Solval, K.M.; Chotiko, A.; Alfaro, L.; Reyes, V.; Liu, C.; Dzandu, B.; Kyereh, E.; Barnaby, A.G.; Thompson, I. Microencapsulation of ginger (Zingiber officinale) extract by spray drying technology. LWT-Food Sci. Technol. 2016, 70, 119–125. [Google Scholar] [CrossRef]
- Rialita, T.; Nurhadi, B.; Puteri, R.D. Characteristics of microcapsule of red ginger (Zingiber officinale var Rubrum) essential oil produced from different Arabic gum ratios on antimicrobial activity toward Escherichia coli and Staphylococcus aureus. Int. J. Food Prop. 2018, 21, 2500–2508. [Google Scholar] [CrossRef] [Green Version]
- Zhang, H.C.; Jung, J.; Zhao, Y.Y. Preparation and characterization of cellulose nanocrystals films incorporated with essential oil loaded beta-chitosan beads. Food hydrocolloids 2017, 69, 164–172. [Google Scholar] [CrossRef]
- Noshirvani, N.; Ghanbarzadeh, B.; Gardrat, C.; Rezaei, M.R.; Hashemi, M.; Le Coz, C.; Coma, V. Cinnamon and ginger essential oils to improve antifungal, physical and mechanical properties of chitosan-carboxymethyl cellulose films. Food Hydrocoll. 2017, 70, 36–45. [Google Scholar] [CrossRef]
- Alexandre, E.M.C.; Lourenco, R.V.; Bittante, A.M.Q.B.; Moraes, I.C.F.; Sobral, P.J.A. Gelatin-based films reinforced with montmorillonite and activated with nanoemulsion of ginger essential oil for food packaging applications. Food Packag. Shelf Life 2016, 10, 87–96. [Google Scholar] [CrossRef]
- Pires, J.R.A.; de Souza, V.G.L.; Fernando, A.L. Chitosan/ montmorillonite bionanocomposites incorporated with rosemary and ginger essential oil as packaging for fresh poultry meat. Food Packag. Shelf Life 2018, 17, 142–149. [Google Scholar] [CrossRef]
- Oliveira, C.D.; Gomes, B.D.; Batista, A.F.P.; Mikcha, J.M.G.; Yamashita, F.; Scapim, M.R.S.; Bergamasco, R.D. Development of sorbic acid microcapsules and application in starch-poly (butylene adipate co-terephthalate) films. J. Food Process. Preserv. 2021, 45, e15459. [Google Scholar] [CrossRef]
- Talon, E.; Vargas, M.; Chiralt, A.; Gonzalez-Martinez, C. Eugenol incorporation into thermoprocessed starch films using different encapsulating materials. Food Packag. Shelf Life 2019, 21, 100326. [Google Scholar] [CrossRef]
- Yuan, L.Y.; Feng, W.; Zhang, Z.; Peng, Y.Y.; Xiao, Y.; Chen, J.P. Effect of potato starch-based antibacterial composite films with thyme oil microemulsion or microcapsule on shelf life of chilled meat. LWT-Food Sci. Technol. 2021, 139, 110462. [Google Scholar] [CrossRef]
- De Medeiros, J.A.S.; Blick, A.P.; Galindo, M.V.; Alvim, I.D.; Yamashita, F.; Ueno, C.T.; Shirai, M.A.; Grosso, C.R.F.; Corradini, E.; Sakanaka, L.S. Incorporation of oregano essential oil microcapsules in starch-poly (butylene adipate co-terephthalate) (PBAT) films. Macromol. Symp. 2019, 383, 1800052. [Google Scholar] [CrossRef] [Green Version]
- Da Cruz, M.C.B.; Dagostin, J.L.A.; Perussello, C.A.; Masson, M.L. Assessment of physicochemical characteristics, thermal stability and release profile of ascorbic acid microcapsules obtained by complex coacervation. Food Hydrocoll. 2019, 87, 71–82. [Google Scholar] [CrossRef]
- Eom, H.; Chang, Y.; Lee, E.S.; Choi, H.D.; Han, J. Development of a starch/gum-based edible coating for rice cakes to retard retrogradation during storage. LWT-Food Sci. Technol. 2018, 97, 516–522. [Google Scholar] [CrossRef]
- Zhang, D.L.; Cao, Y.F.; Ma, C.Y.; Chen, S.F.; Li, H.J. Development of water-triggered chitosan film containing glucamylase for sustained release of resveratrol. J. Agric. Food Chem. 2017, 65, 2503–2512. [Google Scholar] [CrossRef]
- Arfat, Y.A.; Ahmed, J.; Hiremath, N.; Auras, R.; Joseph, A. Thermo-mechanical, rheological, structural and antimicrobial properties of bionanocomposite films based on fish skin gelatin and silver-copper nanoparticles. Food Hydrocoll. 2017, 62, 191–202. [Google Scholar] [CrossRef]
- Anker, M.; Stading, M.; Hermansson, A.M. Aging of whey protein films and the effect on mechanical and barrier properties. J. Agric. Food Chem. 2001, 49, 989–995. [Google Scholar] [CrossRef] [PubMed]
- Wang, Z.; Sun, X.X.; Lian, Z.X.; Wang, X.X.; Zhou, J.; Ma, Z.S. The effects of ultrasonic/microwave assisted treatment on the properties of soy protein isolate/microcrystalline wheat-bran cellulose film. J. Food Eng. 2013, 114, 183–191. [Google Scholar] [CrossRef]
- Cai, C.C.; Ma, R.J.; Duan, M.W.; Deng, Y.F.; Liu, T.; Lu, D.J. Effect of starch film containing thyme essential oil microcapsules on physicochemical activity of mango. LWT-Food Sci. Technol. 2020, 131, 109700. [Google Scholar] [CrossRef]
- Esmaeili, A.; Asgari, A. In vitro release and biological activities of Carum copticum essential oil (CEO) loaded chitosan nanoparticles. Int. J. Biol. Macromol. 2015, 81, 283–290. [Google Scholar] [CrossRef]
- Loyeau, P.A.; Spotti, M.J.; Vanden Braber, N.L.; Rossi, Y.E.; Montenegro, M.A.; Vinderola, G.; Carrara, C.R. Microencapsulation of Bifidobacterium animalis subsp lactis INL1 using whey proteins and dextrans conjugates as wall materials. Food Hydrocoll. 2018, 85, 129–135. [Google Scholar] [CrossRef]
- Peng, C.; Zhao, S.Q.; Zhang, J.; Huang, G.Y.; Chen, L.Y.; Zhao, F.Y. Chemical composition, antimicrobial property and microencapsulation of mustard (sinapis alba) seed essential oil by complex coacervation. Food Chem. 2014, 165, 560–568. [Google Scholar] [CrossRef]
- Wang, L.X.; Yang, S.W.; Cao, J.L.; Zhao, S.H.; Wang, W.W. Microencapsulation of ginger volatile oil based on gelatin/sodium alginate polyelectrolyte complex. Chem. Pharm. Bull. 2016, 64, 21–26. [Google Scholar] [CrossRef] [Green Version]
- Ocak, B. Gum arabic and collagen hydrolysate extracted from hide fleshing wastes as novel wall materials for microencapsulation of Origanum onites L. essential oil through complex coacervation. Environ. Sci. Pollut. Res. 2020, 27, 42727–42737. [Google Scholar] [CrossRef]
- Cai, C.C.; Ma, R.J.; Duan, M.W.; Lu, D.J. Preparation and antimicrobial activity of thyme essential oil microcapsules prepared with gum arabic. RSC Adv. 2019, 9, 19740–19747. [Google Scholar] [CrossRef] [Green Version]
- Mukherjee, I.; Rosolen, M. Thermal transitions of gelatin evaluated using DSC sample pans of various seal integrities. J. Therm. Anal. Calorim. 2013, 114, 1161–1166. [Google Scholar] [CrossRef]
- Mansour, M.; Salah, M.; Xu, X.Y. Effect of microencapsulation using soy protein isolate and gum arabic as wall material on red raspberry anthocyanin stability, characterization, and simulated gastrointestinal conditions. Ultrason. Sonochemistry 2020, 63, 104927. [Google Scholar] [CrossRef] [PubMed]
- Wang, J.; Ren, F.Z.; Shang, J.J.; Leng, X.J. Effects of Plasticizers on properties of whey protein-sericin blended edible films. Food Sci. 2008, 6, 59–63. [Google Scholar]
- Anwar, S.H.; Kunz, B. The influence of drying methods on the stabilization of fish oil microcapsules: Comparison of spray granulation, spray drying, and freeze drying. J. Food Eng. 2011, 105, 367–378. [Google Scholar] [CrossRef]
- Schmitt, C.; Turgeon, S.L. Protein/polysaccharide complexes and coacervates in food systems. Adv. Colloid Interface Sci. 2011, 167, 63–70. [Google Scholar] [CrossRef] [PubMed]
- Turgeon, S.L.; Schmitt, C.; Sanchez, C. Protein–polysaccharide complexes and coacervates. Curr. Opin. Colloid Interface Sci. 2007, 12, 166–178. [Google Scholar] [CrossRef]
- Rutz, J.K.; Borges, C.D.; Zambiazi, R.C.; Crizel-Cardozo, M.M.; Kuck, L.S.; Norena, C.P.Z. Microencapsulation of palm oil by complex coacervation for application in food systems. Food Chem. 2017, 220, 59–66. [Google Scholar] [CrossRef]
- Favaro-Trindade, C.S.; Santana, A.S.; Monterrey-Quintero, E.S.; Trindade, M.A.; Netto, F.M. The use of spray drying technology to reduce bitter taste of casein hydrolysate. Food Hydrocoll. 2010, 24, 336–340. [Google Scholar] [CrossRef]
- Rajabi, H.; Ghorbani, M.; Jafari, S.M.; Mahoonak, A.S.; Rajabzadeh, G. Retention of saffron bioactive components by spray drying encapsulation using maltodextrin, gum arabic and gelatin as wall materials. Food Hydrocoll. 2015, 51, 327–337. [Google Scholar] [CrossRef]
- Awika, J.M.; Rooney, L.W.; Wu, X.L.; Prior, R.L.; Cisneros-Zevallos, L. Screening methods to measure antioxidant activity of sorghum (Sorghum bicolor) and sorghum products. J. Agric. Food Chem. 2003, 51, 6657–6662. [Google Scholar] [CrossRef] [PubMed]
- Zhang, J.L.; Kowaleguet, M.G.; Ban, Z.J.; Liu, H.D.; Wang, Y.J. Research progress on antimicrobial activity of ginger essential oil and its application in food. Food Ind. 2020, 41, 273–376. [Google Scholar]

| Gelatin (g/100 mL) | Gelatin: Glycerin Ratio | Drying Conditions | Ginger Essential Oil Microcapsules (g/100 mL) | Elongation at Break (%) | Thickness (mm) | |
|---|---|---|---|---|---|---|
| Temperature (℃) | Time (h) | |||||
| 2 | 1:0.3 | 20 | 48 | 1.36 | —— | —— |
| 4 | 1:0.3 | 20 | 48 | 1.36 | 40.5 ± 0.9 b | 0.14 ± 0.03 c |
| 6 | 1:0.3 | 20 | 48 | 1.36 | 45.0 ± 0.5 a | 0.21 ± 0.02 b |
| 8 | 1:0.3 | 20 | 48 | 1.36 | 40.0 ± 0.8 b | 0.29 ± 0.02 a |
| 10 | 1:0.3 | 20 | 48 | 1.36 | —— | —— |
| 6 | 1:0.2 | 20 | 48 | 1.36 | 19.2 ± 0.5 c | 0.20 ± 0.02 c |
| 6 | 1:0.3 | 20 | 48 | 1.36 | 45.0 ± 0.5 b | 0.21 ± 0.02 b |
| 6 | 1:0.4 | 20 | 48 | 1.36 | 47.2 ± 0.6 a | 0.22 ± 0.01 a |
| 6 | 1:0.5 | 20 | 48 | 1.36 | —— | —— |
| 6 | 1:0.3 | 20 | 48 | 1.36 | 45.0 ± 0.5 | 0.21 ± 0.02 |
| 6 | 1:0.3 | 30 | 30 | 1.36 | —— | —— |
| 6 | 1:0.3 | 40 | 12 | 1.36 | —— | —— |
| 6 | 1:0.3 | 20 | 48 | 0.34 | 59.3 ± 1.0 a | 0.13 ± 0.02 d |
| 6 | 1:0.3 | 20 | 48 | 0.85 | 47.9 ± 0.8 b | 0.18 ± 0.02 c |
| 6 | 1:0.3 | 20 | 48 | 1.36 | 45.0 ± 0.5 c | 0.21 ± 0.02 b |
| 6 | 1:0.3 | 20 | 48 | 1.87 | 20.4 ± 1.4 d | 0.29 ± 0.02 a |
| 6 | 1:0.3 | 20 | 48 | 2.38 | —— | —— |
| Ginger Essential Oil Microcapsules (g/100 mL) | Tensile Strength (MPa) | Oxygen Permeability (10−5 cm3 m−2 d−1 Pa−1) |
|---|---|---|
| 0 | 35.45 ± 0.25 a | 2.3 ± 0.1 b |
| 0.34 | 30.04 ± 0.41 b | 2.0 ± 0.1 c |
| 0.85 | 26.51 ± 0.34 c | 1.5 ± 0.2 d |
| 1.36 | 25.03 ± 0.65 d | 1.4 ± 0.1 d |
| 1.87 | 19.19 ± 0.50 e | 3.1 ± 0.2 a |
| Dosage of Microcapsules (mg) | Diameter of Bacteriostatic Zone (mm) | ||
| Escherichia coli | Staphylococcus aureus | Bacillus subtilis | |
| 0 | —— | —— | —— |
| 5 | 6.19 ± 0.38 a | 5.72 ± 0.21 a | 5.99 ± 0.23 a |
| 10 | 6.94 ± 0.28 b | 6.15 ± 0.19 b | 6.82 ± 0.26 b |
| 15 | 8.14 ± 0.33 c | 7.28 ± 0.30 c | 7.69 ± 0.35 c |
Publisher’s Note: MDPI stays neutral with regard to jurisdictional claims in published maps and institutional affiliations. |
© 2021 by the authors. Licensee MDPI, Basel, Switzerland. This article is an open access article distributed under the terms and conditions of the Creative Commons Attribution (CC BY) license (https://creativecommons.org/licenses/by/4.0/).
Share and Cite
Wang, H.-H.; Li, M.-Y.; Dong, Z.-Y.; Zhang, T.-H.; Yu, Q.-Y. Preparation and Characterization of Ginger Essential Oil Microcapsule Composite Films. Foods 2021, 10, 2268. https://doi.org/10.3390/foods10102268
Wang H-H, Li M-Y, Dong Z-Y, Zhang T-H, Yu Q-Y. Preparation and Characterization of Ginger Essential Oil Microcapsule Composite Films. Foods. 2021; 10(10):2268. https://doi.org/10.3390/foods10102268
Chicago/Turabian StyleWang, Hua-Hua, Meng-Yao Li, Zhou-Yong Dong, Tie-Hua Zhang, and Qing-Yu Yu. 2021. "Preparation and Characterization of Ginger Essential Oil Microcapsule Composite Films" Foods 10, no. 10: 2268. https://doi.org/10.3390/foods10102268
APA StyleWang, H.-H., Li, M.-Y., Dong, Z.-Y., Zhang, T.-H., & Yu, Q.-Y. (2021). Preparation and Characterization of Ginger Essential Oil Microcapsule Composite Films. Foods, 10(10), 2268. https://doi.org/10.3390/foods10102268

